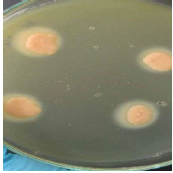

Journal Info
Make a Submission
International Journal

Information
Keywords
Meet our Editorial Board Member

Dao Chanh Thuc, PhD
Vietnam National University, Ho Chi Minh City, VIETNAM
ID Scopus: 57483939800
ID ORCID: https://orcid.org/0000-0002-2822-049X
ID ORCID: https://orcid.org/0000-0002-2822-049X

Dr.Imad Hadi Hamid
Specialization according to the classification, general and specific specialization:
single technologies
single technologies
He learned and acquired history: Assistant Professor 3-19-2015
Last academic degree I obtained: Ph.D.
Last academic degree I obtained: Ph.D.

Professor Dr. Nasir Muwfaq Younis
College of Nursing /University of Mosul, Iraq.
Author ID:57218263295
Scopus ID: www.scopus.com
H.index in Scopus:22
Author ID:57218263295
Scopus ID: www.scopus.com
H.index in Scopus:22

Marisa Salvi
Email: salvimarisa21@gmail.com.
ORCID : 0000-0003-2434-3393
UFMG - Federal University of Minas Gerais
Department of Morphology
Belo Horizonte, Minas Gerais, Brazil

Hadeel Rasheed Seger
Email: E-mail:hadeel.r@uokerbala.edu.iq
Ph.D in maternal and child health nursing
University of Kerbala, faculty of nursing
https://scholar.google.com/citations?user=HbrQMaAAAAAJ&hl=en
https://www.scopus.com/authid/detail.uri?authorId=57204561868